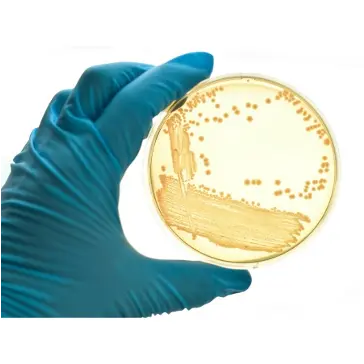

Excelencia en Microbiología con Oxoid:
Oxoid es un fabricante líder de productos de microbiología utilizados en investigación, diagnóstico clínico y pruebas de seguridad alimentaria. Reconocida por su excelencia en el campo, Oxoid proporciona productos de alta calidad que son esenciales para una variedad de aplicaciones en laboratorios de todo el mundo.

Colaboración Estratégica con BDC Serralles:
Con más de 40 años de experiencia en el mercado, BDC Serralles se destaca como un proveedor líder de reactivos y equipos químicos de alta calidad. Trabajando en estrecha colaboración con grandes empresas en el mercado, nos esforzamos por ofrecer productos de calidad y durabilidad a nuestros clientes. Como socios de Oxoid, nos comprometemos a proporcionar una amplia variedad de productos para laboratorios, hospitales e instituciones de investigación, garantizando que nuestros clientes tengan acceso a los productos más avanzados y confiables disponibles.

Productos Esenciales para Laboratorios:
A través de BDC Serralles y la marca Oxoid, ofrecemos una amplia gama de productos y reactivos químicos para la investigación científica, el control de calidad industrial y la educación. Nuestra oferta incluye medios de cultivo y caldos para el crecimiento de microorganismos, reactivos y kits para diversas pruebas de diagnóstico, productos de biología molecular para el análisis de ADN y ARN, así como instrumentos para pruebas microbiológicas automatizadas.




